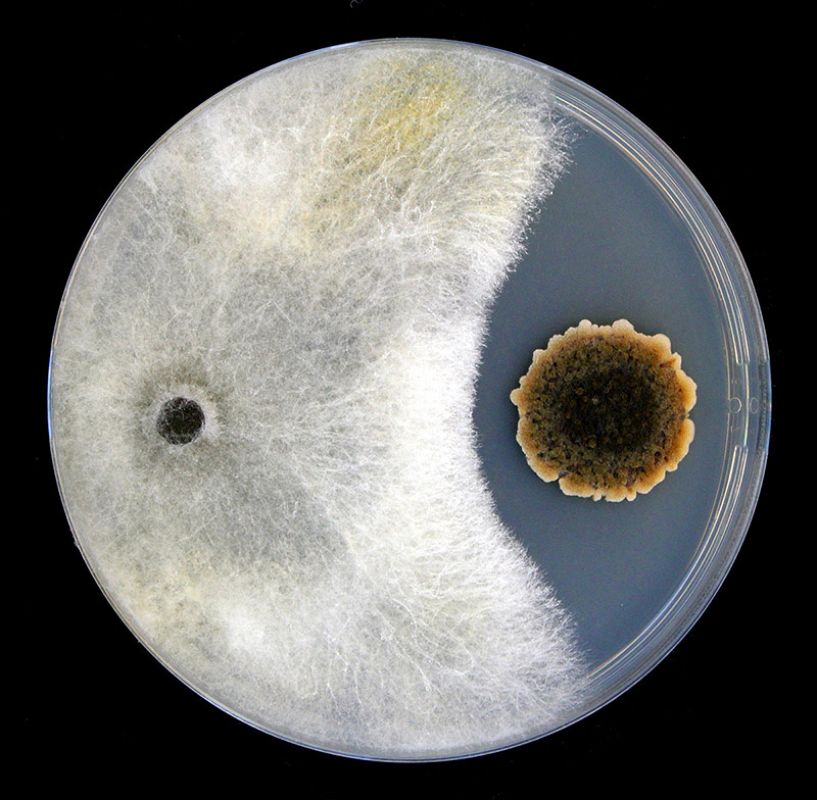
'Competencia fúngica', fotografía seleccionada en la modalidad sobre agricultura sostenible

Fotografías ganadoras de la 15ª edición de Fotciencia
-

'Maravillas del micromundo', fotografía seleccionada en la modalidad micro
21.01.2018En esta imagen podemos observar pirámides de Seleniuro de Indio que fueron formadas por el sucesivo crecimiento y apilamiento de capas hasta alcanzar la altura de cerca de un micrómetro, lo que supone 8 órdenes de magnitud menos que la Pirámide de Keops.Carlos López Pernía -

'El vuelo de la libélula', fotografía seleccionada en la modalidad micro
21.01.2018En la microfotografía se observa un detalle de las alas de una libélula, maravilla de la ingeniería natural e inspiración para los drones del futuro.María Carbajo Sánchez -
'Competencia fúngica', fotografía seleccionada en la modalidad sobre agricultura sostenible
21.01.2018La técnica del co-cultivo permite simular in vitro las interacciones entre microorganismos que pueden darse en su entorno natural. La especie endófita Dothiora sp. (hongo negro) se enfrentó a la cepa fitopatógena Hypoxylon mediterraneum (hongo blanco) en una placa de Petri de 90 mm de diámetro con medio de agar de malta al 2% durante 14 días a 22 °C de temperatura. Ambos microorganismos podrían estar detectando la presencia del otro a través de señales difusibles en el medio, generando una reacción antagónica que inhibe el crecimiento de dicho patógeno.Rachel Serrano
Últimas fotogalerías Noticias
Ver más















